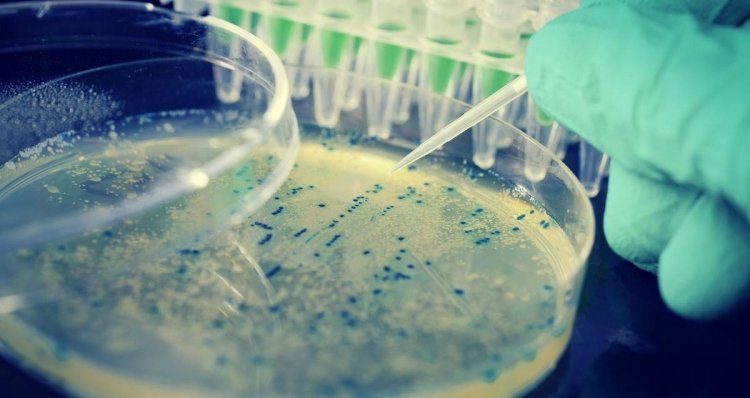

Tehéntúró okozhatta a tömeges megbetegedést Argeș megyében
A hatóságok 20 kilogramm E. colival fertőzött tehéntúrót találtak. Nem csak ez lehet a kisgyermekek hasmenésének kizárólagos oka.
Az állat-egészségügyi és élelmiszerbiztonsági hatóság (ANSVSA) és a közegészségügyi hivatal (DSP) szakemberei a napokban Argeş és Dolj megyében különböző forgalomban lévő élelmiszereket – tej- és hústermékeket, zöldségeket és gyümölcsöket – vizsgáltak meg, hogy kiderítsék, mi okozza a kisgyermekek tömeges megbetegedését. Ugyanakkor magángazdaságokból is mintákat vettek.
A 194 mintából mindeddig két esetben mutatták ki az E. coli 026-os variánsát: egy bacăui magánszemély hűtőjében tárolt csirkehúsban, és 20 kilogramm tehéntúróban az egyik Argeş megyei üzletben. A szakemberek azonnali hatállyal felfüggesztették a termelést abban az üzemben, ahonnan származott, és elrendelték az előállításban használt gépek fertőtlenítését, illetve a személyzet kivizsgálását. Bakteorológiai vizsgálatnak vetik alá a kistermelő által használt vizet, és a két beszállító gazda által leadott tejet is.
A bukaresti Marie Curie kórházban hemolitikus urémiás szindrómával kezelt hat kisbaba közül egyet hétfőn kiengedtek, a többiek stabil állapotban vannak. Az a gyermek, akit kórházra kórházra küldözgettek az orvosok, úgy tűnik, idegi károsodást szenvedett.
A Dacian Cioloş kormányfő által elrendelt vizsgálatok számos rendellenességre mutattak rá a Piteşti-i gyermekkórházban, ahol a legtöbb hasmenéses gyermeket ápolják. Többek között a kórházi (nozokómiális) fertőzések számának nyilvántartását hanyagolták el.
Az egészségügyi minisztérium a további megbetegedések megakadályozása érdekében összeírta azokat a higiéniai szabályokat, melyek betartásával elkerülhető a gyerekek megbetegedése. A dokumentumot az oktatási intézményekben fogják terjeszteni.
Mint ismeretes, Argeș megyében vasárnap 45-re emelkedett az akut hasmenés miatt beutalt csecsemők száma. Három gyermek vesztette életét az E. coli baktériummal összefüggésben hozható hemolitikus urémiás szindróma miatt.
Generációk ellopott ifjúsága, avagy egy John Lydon nevű öreg punk a színpadon
Szántai János
Az öreg punk elővarázsolt egy fiatalembert, aki dühösen kérdőre vonta a közönséget. És nem tudtuk elmondani, hova lett a repülőgép, az Északi-sark, a büszke és szabad Magyarország és a többi…
Demeter András kicsinálása – szempontok egy igen gyorsan levezényelt, virtuóz akcióhoz
Fall Sándor
Azt nem tudni, hogy a lemondott miniszter ellen kik tervelték ki és hajtották végre az akciót, elképzelhető, hogy ez soha nem is fog kiderülni.
Az egyesült Nagy-Románia máig nem jelent egységesítést
Sólyom István
A mítosztalanított román–magyar közös történelem nem széles körű fogyasztásra alkalmas termék, de az MCC-történészkerekasztal előadói egyelőre optimisták.
„De hát én erdélyi vagyok, na” – a 90 éves Bodor Ádámot köszöntötték Kolozsváron
Varga László Edgár
Az író többek között arról beszélt, hogy ő „csak betévedt” az irodalomba, és arról is, milyen ambivalens érzésekkel tölti el a szülővárosába való visszatérés.

Száz nyestbőrrel a batyujában akart beutazni Romániába egy ukrán állampolgár – hírmix
Több mint félmilliárd lej eltitkolt vagyonra derített fényt az ANAF legújabb ellenőrzése. Népszavazással váltottak le egy Maros megyei polgármestert.

Elítélték Temesvár német polgármesterét, emiatt 2030-ig nem indulhat választáson
Jogerősen is pert vesztett a legfelsőbb bíróságon Dominic Fritz temesvári polgármester az őt érdekellentéttel vádoló Országos Feddhetetlenségi Ügynökséggel (ANI) szemben.

Nicușor Dan, a projektország hasznos idiótája
Többször leírtam: Románia egy projektország. Na és ebben a projektországban akkor van demokrácia, amikor a projekt megkívánja. Amikor nem, akkor nincs.

Elpusztított egy lovat és jött a tehénért is a behemót medve, amikor kilőtték
Kilőttek azt a medvét Gyergyószárhegy községben péntek hajnalban, amelyik az elmúlt napokban több alkalommal visszatért egy esztenához és haszonállatokat pusztított el.
Tanasă most éppen nem a magyaroknak ment neki
Kettős mérce alkalmazásával vádolta meg a Nemzeti Liberális Pártot (PNL) és a Mentsétek meg Romániát Szövetséget (USR) a magyarellenes kirohanásairól hírhedtté vált Dan Tanasă, a szélsőjobboldlai Románok Egyesüléséért Szövetség (AUR) képviselője.

A napenergia fedezte a fogyasztás 70 százalékát, mégsem lett olcsóbb az áram
Péntek délben a napenergia fedezte Románia villamosenergia-fogyasztásának mintegy 70 százalékát, ez azonban nem jelentett olcsóbb áramot a fogyasztóknak – állapította meg elemzésében Dumitru Chisăliță, az Intelligens Energia Egyesület (AEI) elnöke.

Ilie Bolojan lett újból a PNL elnöke. Jövőtől öt évre lezárják a Karánsebes–Szörényvár vasútvonalat felújítás miatt – hírek
Ludovic Orban pedig visszatérne a PNL-be.

Ilie Bolojan lett újból a PNL elnöke. Jövőtől öt évre lezárják a Karánsebes–Szörényvár vasútvonalat felújítás miatt – hírek
Ludovic Orban pedig visszatérne a PNL-be.

Mégsem indul a PNL elnöki tisztségéért vasárnap Adrian Veștea – hírek szombaton
További híreink: hatvannyolcszoros, jobban mondva százharminchatszoros kutyafülcsonkításért állhat bíróság elé egy férfi, keddig pedig csak a záporok, szélviharok szakítják meg a kánikulát.

Mégsem indul a PNL elnöki tisztségéért vasárnap Adrian Veștea – hírek szombaton
További híreink: hatvannyolcszoros, jobban mondva százharminchatszoros kutyafülcsonkításért állhat bíróság elé egy férfi, keddig pedig csak a záporok, szélviharok szakítják meg a kánikulát.

Nicușor Dant Brüsszelből nem érdekli, hogy az AUR szavazataival állhat fel az új kormány…
… egy PNL-s főembert elvitt a DNA, az USR elnökére lesújtott Justitia kardja, az RMDSZ-re a botránytévék hányják a gyűlöletet… és tíz román állampolgár egymillió eurónyi drótot lopott Németországban.

Nicușor Dant Brüsszelből nem érdekli, hogy az AUR szavazataival állhat fel az új kormány…
… egy PNL-s főembert elvitt a DNA, az USR elnökére lesújtott Justitia kardja, az RMDSZ-re a botránytévék hányják a gyűlöletet… és tíz román állampolgár egymillió eurónyi drótot lopott Németországban.

Akkora a kupi kormányalakítás körül, hogy ember legyen a talpán, aki átlátja – hírek csütörtökön
Közben Románia Szlovákiával közösen kéri, hogy az Európai Bizottság lazítson a medvéket védő szabályozásokon. Nyárádszeredában pedig tranzitdíjat vezettek be a kamionokra, a lépés az ott épülő autópályát is érinti.

Akkora a kupi kormányalakítás körül, hogy ember legyen a talpán, aki átlátja – hírek csütörtökön
Közben Románia Szlovákiával közösen kéri, hogy az Európai Bizottság lazítson a medvéket védő szabályozásokon. Nyárádszeredában pedig tranzitdíjat vezettek be a kamionokra, a lépés az ott épülő autópályát is érinti.

Kiengedték a börtönből Horațiu Potrát, Călin Georgescu zsoldosvezérét – hírmix
További híreink: a jelek szerint Adrian Veștea kormányalakítási kísérlete is halva született, de legalább egyre nagyobb a káosz, ha pedig súlyos inflációról van szó, Románia mindenkit toronymagasan megelőz.

Kiengedték a börtönből Horațiu Potrát, Călin Georgescu zsoldosvezérét – hírmix
További híreink: a jelek szerint Adrian Veștea kormányalakítási kísérlete is halva született, de legalább egyre nagyobb a káosz, ha pedig súlyos inflációról van szó, Románia mindenkit toronymagasan megelőz.

Nem támogatja az RMDSZ Veșteát, két új forgatókönyv is körvonalazódik kormányalakításra – hírmix
Szennyezett kavicsot használtak fel útjavításra egy Bihar megyei faluban, feljelentették a polgármestert. A romániai textilipar súlyos megrendelési visszaesésekkel küzd egy EU-s szabályozást követően.

Nem támogatja az RMDSZ Veșteát, két új forgatókönyv is körvonalazódik kormányalakításra – hírmix
Szennyezett kavicsot használtak fel útjavításra egy Bihar megyei faluban, feljelentették a polgármestert. A romániai textilipar súlyos megrendelési visszaesésekkel küzd egy EU-s szabályozást követően.

Száz nyestbőrrel a batyujában akart beutazni Romániába egy ukrán állampolgár – hírmix
Több mint félmilliárd lej eltitkolt vagyonra derített fényt az ANAF legújabb ellenőrzése. Népszavazással váltottak le egy Maros megyei polgármestert.

Száz nyestbőrrel a batyujában akart beutazni Romániába egy ukrán állampolgár – hírmix
Több mint félmilliárd lej eltitkolt vagyonra derített fényt az ANAF legújabb ellenőrzése. Népszavazással váltottak le egy Maros megyei polgármestert.

Adrian Veștea PNL-s politikust kérte fel az államfő kormányalakításra, a párt megkérdezése nélkül – hírek
Előbb esőzések és szélviharok, aztán kánikula jön országszerte. Továbbá sikerült kompromisszumot kötni a lengyel gyártóval: a pályaudvaron rekedt új vonatokat napokon belül üzembe helyezik.

Adrian Veștea PNL-s politikust kérte fel az államfő kormányalakításra, a párt megkérdezése nélkül – hírek
Előbb esőzések és szélviharok, aztán kánikula jön országszerte. Továbbá sikerült kompromisszumot kötni a lengyel gyártóval: a pályaudvaron rekedt új vonatokat napokon belül üzembe helyezik.

Rossz napjai vannak Eugen Tomacnak: az USR és úgy hírlik, az RMDSZ is hátat fordított neki…
… leomlott a szászmuzsnai evangélikus erődtemplom falának egy része… és nyolc év után hamarosan új autópálya-szakaszt avatnak Erdélyben, ha minden jól megy.

Rossz napjai vannak Eugen Tomacnak: az USR és úgy hírlik, az RMDSZ is hátat fordított neki…
… leomlott a szászmuzsnai evangélikus erődtemplom falának egy része… és nyolc év után hamarosan új autópálya-szakaszt avatnak Erdélyben, ha minden jól megy.

A hűtőbe is benézett a nyolc házat feldúló medve – hírmix
A kőolaj- és földgázkitermelésben dolgozók keresnek a legjobban Romániában. Ezentúl akár 12 000 lejre is megbírságolhatják a csendháborítókat.

A hűtőbe is benézett a nyolc házat feldúló medve – hírmix
A kőolaj- és földgázkitermelésben dolgozók keresnek a legjobban Romániában. Ezentúl akár 12 000 lejre is megbírságolhatják a csendháborítókat.
Generációk ellopott ifjúsága, avagy egy John Lydon nevű öreg punk a színpadon
Szántai János
Az öreg punk elővarázsolt egy fiatalembert, aki dühösen kérdőre vonta a közönséget. És nem tudtuk elmondani, hova lett a repülőgép, az Északi-sark, a büszke és szabad Magyarország és a többi…
Demeter András kicsinálása – szempontok egy igen gyorsan levezényelt, virtuóz akcióhoz
Fall Sándor
Azt nem tudni, hogy a lemondott miniszter ellen kik tervelték ki és hajtották végre az akciót, elképzelhető, hogy ez soha nem is fog kiderülni.
Az egyesült Nagy-Románia máig nem jelent egységesítést
Sólyom István
A mítosztalanított román–magyar közös történelem nem széles körű fogyasztásra alkalmas termék, de az MCC-történészkerekasztal előadói egyelőre optimisták.
„De hát én erdélyi vagyok, na” – a 90 éves Bodor Ádámot köszöntötték Kolozsváron
Varga László Edgár
Az író többek között arról beszélt, hogy ő „csak betévedt” az irodalomba, és arról is, milyen ambivalens érzésekkel tölti el a szülővárosába való visszatérés.







